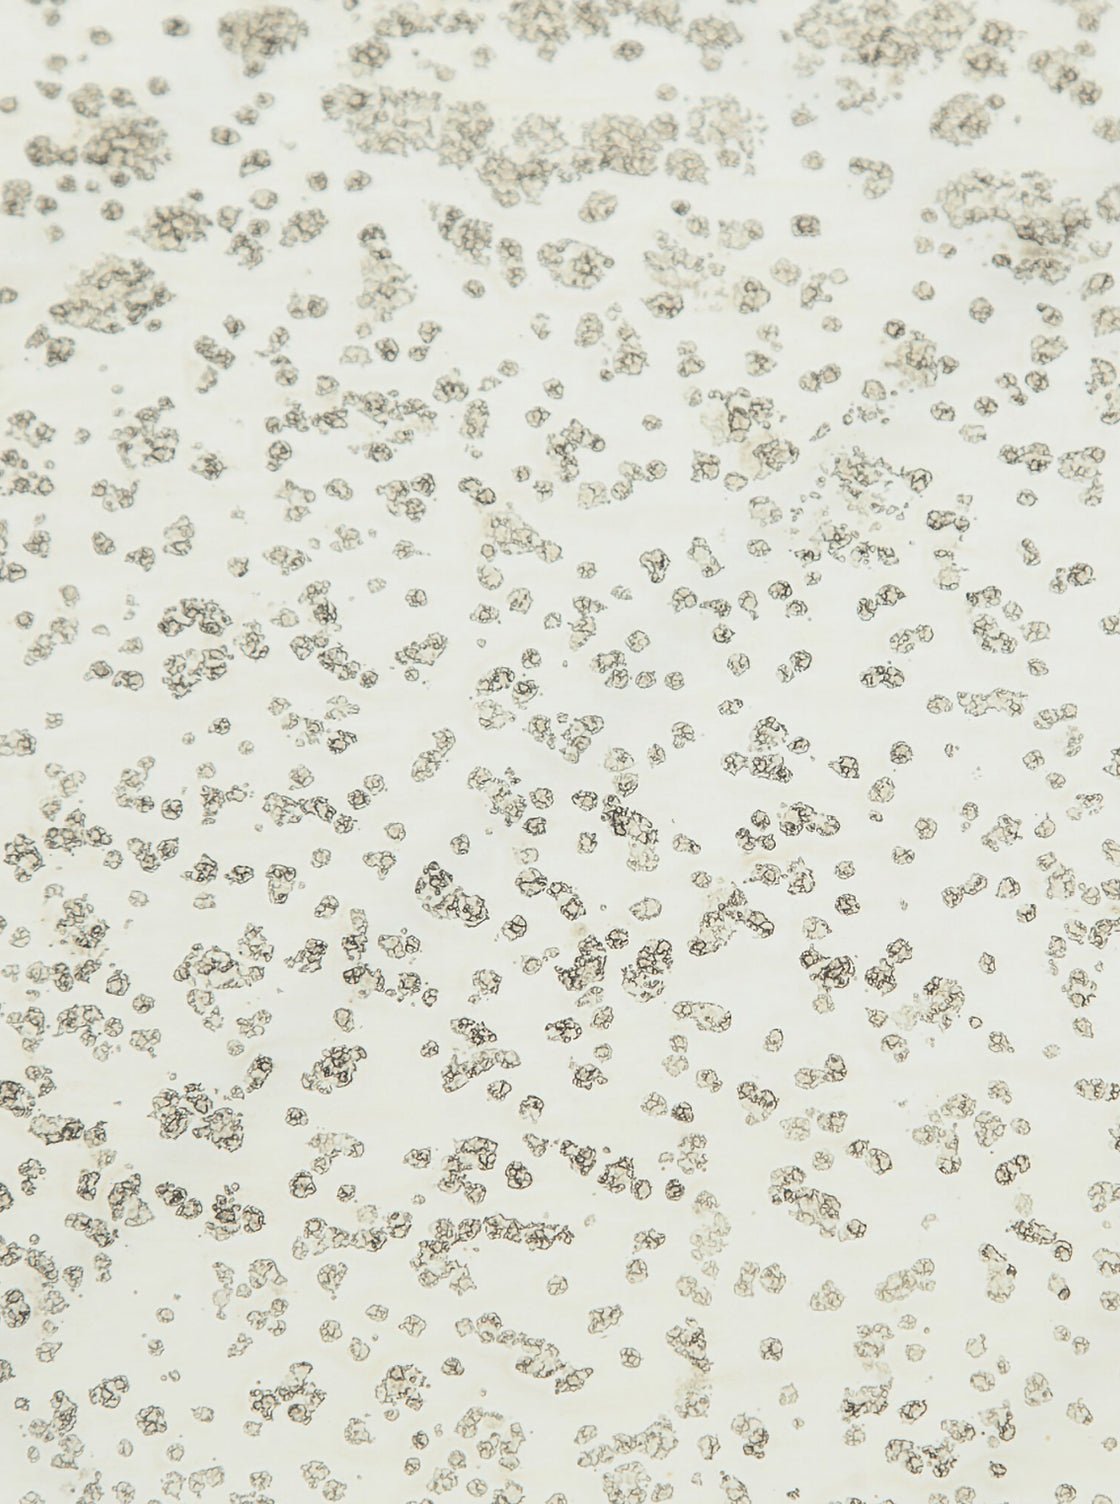
Table d'appoint Bridger

Tables d'appoint
-
Table d'appoint Cory -
Table d'appoint Corey -
Table d'appoint Clifford -
Table de chevet Charles -
Table d'appoint Carina -
Table d'appoint Cadigan -
Table d'appoint Cadence -
Table d'appoint Brienne -
Table d'appoint Bridger -
Table d'appoint Brianne -
Table de chevet ovale Brianne -
Table d'appoint Beatrix -
Table d'appoint Auburn -
Table d'appoint Archer -
Table de chevet Amal